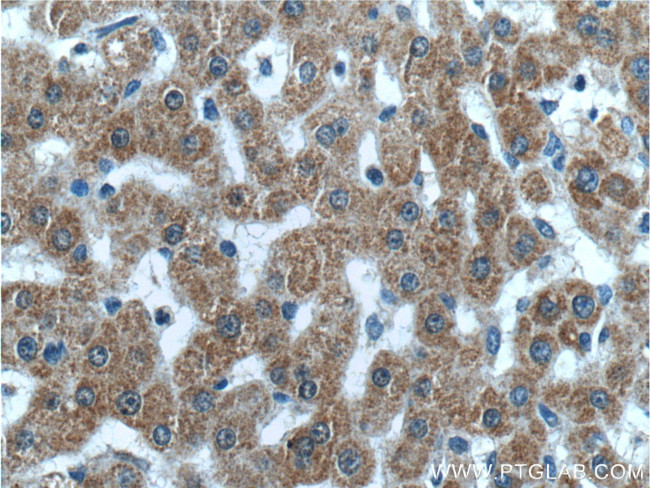
FAM172A Antibody in Immunohistochemistry (Paraffin) (IHC (P))
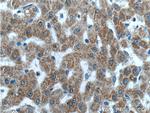
FAM172A Antibody in Immunohistochemistry (Paraffin) (IHC (P))

Search
Proteintech
FAM172A Polyclonal Antibody
{{$productOrderCtrl.translations['antibody.pdp.commerceCard.promotion.promotions']}}
{{$productOrderCtrl.translations['antibody.pdp.commerceCard.promotion.viewpromo']}}
{{$productOrderCtrl.translations['antibody.pdp.commerceCard.promotion.promocode']}}: {{promo.promoCode}} {{promo.promoTitle}} {{promo.promoDescription}}. {{$productOrderCtrl.translations['antibody.pdp.commerceCard.promotion.learnmore']}}
产品信息
24732-1-AP
种属反应
宿主/亚型
分类
类型
抗原
偶联物
形式
纯化类型
保存液
内含物
保存条件
运输条件
产品详细信息
Immunogen sequence: NYIEVEKPKI HVQSSSDSSD EPAEKRERKD KVSKETKKRR DFYEKYRNPQ REKEMMQLYI RENGSPEEHA IYVWDHFIAQ AAAENVFFVA HSYGGLAFVE LMIQREADVK NKVTAVALTD SVHNVWHQEA GKTIREWMRE NCCNWVSSSE PLDTSVESML PDCPRVSAGT DRHELTSWKS FPSIFKFFTE ASEAKTSSLK PAVTRRSHRI KHEEL
靶标信息
FAM172A is a protein coding gene.
仅用于科研。不用于诊断过程。未经明确授权不得转售。
篇参考文献 (0)
生物信息学
蛋白别名: ARB2 cotranscriptional regulator A; Cotranscriptional regulator ARB2A; Cotranscriptional regulator FAM172A; family with sequence similarity 172 member A; family with sequence similarity 172, member A; Protein FAM172A; unnamed protein product
基因别名: 1110033M05Rik; 2610318O14Rik; 53-E6; 9430037D06Rik; AF064782; ARB2A; C5orf21; FAM172A; pEN87; RGD1305526; Toupee
UniProt ID: (Human) Q8WUF8, (Mouse) Q3TNH5
Entrez Gene ID: (Human) 83989, (Mouse) 68675, (Rat) 294606